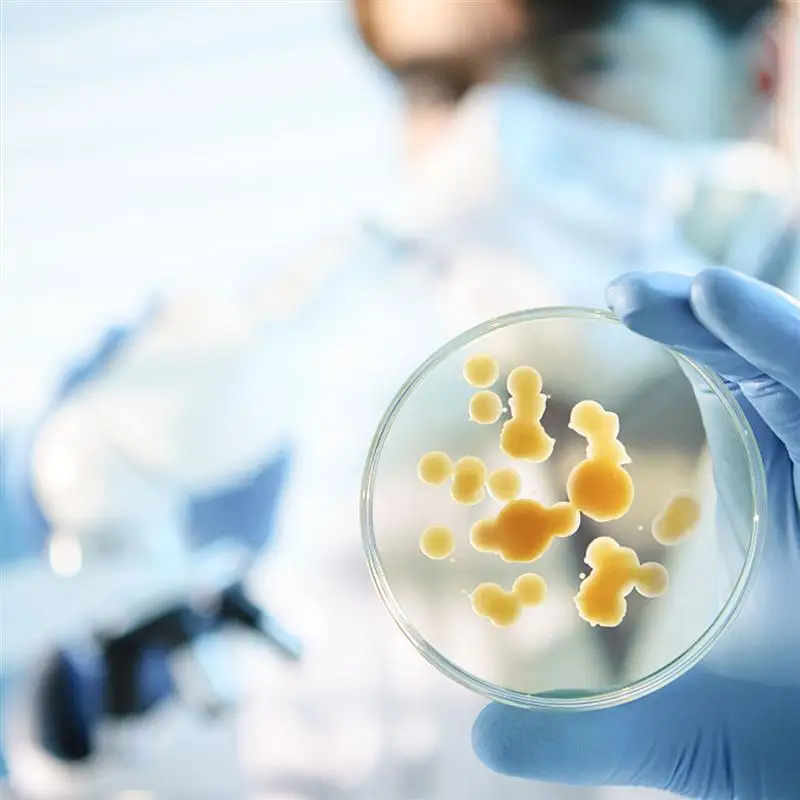

4 шт. лабораторное стекло для часов, устойчивое к высоким температурам, утолщенное стекло для часов, 60 мм + 75 мм + 90 мм + 100 мм 




963,30₽
В наличии!
Последнее обновление: 16.03.2022
Кусачки-пазлы из углеродистой стали, острые кусачки, модель в сборе...
820,80₽
Последнее обновление: 14.09.2024
HYBOLAN вращающаяся блёстка стальная проволока Сделай Сам приманка ...
60,80₽
Последнее обновление: 02.03.2022
Модная прозрачная пластиковая оправа, очки для чтения, пластиковая ...
499,70₽
Последнее обновление: 04.10.2024
Последнее обновление: 11.10.2024
Модные женские очки для чтения, Женские оправы для очков, модные оч...
1 709,05₽
Последнее обновление: 17.09.2024
Зажим датчика угла поворота руля автомобиля для W211 W221 W164 W171...
760,89₽
Последнее обновление: 06.09.2024
Крючок для овариэктомии животных, крючок для стерилизации ветеринар...
1 304,35₽
Последнее обновление: 21.09.2024
Гамак-качели Youpin Zaofeng, Парашютная тканевая койка, максимальна...
1 325,50₽
Последнее обновление: 19.05.2022
Очки для чтения унисекс без оправы из чистого титана, + 25 + 50 + 7...
5 159,45₽
Последнее обновление: 29.05.2022
Точные остроконечные плоскогубцы из углеродистой стали, пазлы, моде...
1 326,20₽
Последнее обновление: 27.04.2022
Кусачки-пазлы из углеродистой стали, острые кусачки, модель в сборе...
805,43₽
Последнее обновление: 16.04.2022
1 шт. Автомобильная муфта мотоцикла Гидравлический Тормозной сливно...
298,66₽
Последнее обновление: 15.05.2022
Дверная ручка багажника для Qashqai 07-14 90812JD00H 90812JD20H 908...
2 240,05₽
Последнее обновление: 07.03.2022
Наклейки для электросамоката Xiaomi, светоотражающие наклейки 1s, д...
741,00₽
Последнее обновление: 14.10.2024
Насадка для душа с удлинителем, 16 дюймов, настенный кронштейн из н...
789,81₽
Последнее обновление: 30.05.2022
Зажим датчика угла рулевого колеса для W211 W241 W171 R300 S300
1 042,96₽
Последнее обновление: 07.04.2022
Новинка, переноска для младенцев, набедренное сиденье, мультяшный м...
888,13₽
Последнее обновление: 24.05.2022
Зажим датчика угла поворота руля для W211 W221 ML W164 W241 W171 ML...
1 792,73₽
Последнее обновление: 13.03.2022
Подвесная кровать-гамак Youpin Zaofeng из парашютной ткани, гамаки ...
2 466,47₽
Последнее обновление: 04.03.2022
Кусачки-пазлы из углеродистой стали, острые кусачки, модель в сборе...
1 134,31₽
Последнее обновление: 26.05.2022
Последнее обновление: 04.10.2024
Кусачки-пазлы из углеродистой стали, острые кусачки, модель в сборе...
752,40₽
Последнее обновление: 05.06.2022
Новый флэш-накопитель, флэш-накопитель 16 ГБ, флэш-накопитель 32 ГБ...
232,75₽
Последнее обновление: 04.04.2022
Набор для ремонта втулок коробки передач ZF6HP19 ZF6HP21, 12 шт., м...
3 596,75₽
Последнее обновление: 19.05.2022
Описание
Вы ищете высококачественное стекло для часов? Наш товар удовлетворит все ваши потребности. Утолщенное стекло обеспечивает большую безопасность, вы можете использовать его с уверенностью. Не сомневайтесь! Приходите и покупайте.
Характеристики
-Цвет: прозрачный
-Материал: стекло
-Размер: около 10x10x1 см/3,93x3,93x0,39 дюйма
-Многофункциональность: можно использовать в качестве емкости для испарения, можно использовать в качестве крышки, можно использовать в качестве контейнера, можно использовать в качестве переноски
-Абсолютно Новое: высококачественное стекло, поэтому вы можете использовать его с уверенностью.
-Высокая прочность и устойчивость к коррозии.
-Высокая прозрачность, легко наблюдать экспериментальные результаты.
-Выгодная цена и длительный срок службы.
Упаковочный лист
4 х очки для часов








Вопросы еще не задавались...